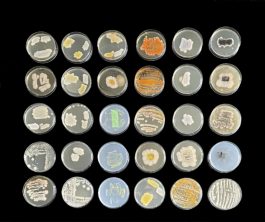
Cyrus Clarke

Interspecies
Gossip

Project Details
Role
Concept creation
Creative direction
Synthetic biology
Bio-design
Scenario writing
Research
Year
2020
Exhibited
Ginkgo Creative Residency
Copernicus Museum

Interspecies gossip is a speculative fantasy and synthetic biology project revealing the conversations within, between and amongst communities of species that go unheard, unseen and undetected by human beings in their own homes.
It is a project comprised of a collection of stories, a set of 'Objects of Attraction' and a guide to a new practice, that might once again connect human beings with the nonhuman kin we live alongside.
The project is a journey through which we encounter chatty viruses, bored bacteria, intoxicated butterflies and heartbroken plants, accompanied by bodily rituals designed to help you get in touch with the nature of the home.
Interspecies Gossip gives a voice to the voiceless, creates a space for reconnection and allows us to indulge in some subversive fun.

Gossip with the multispecies

The first part of the project is a set of short stories, told from the perspective of gossiping organisms. While we might think gossip is a strictly human affair, other species do love to gossip.
They share stories about their past. Their love lives. Their darkest fears. Their hopes. They even gossip about the humans who live amongst them.
They use various languages and dialects ranging from chemical signatures, alluring odours and inaudible audio. Their conversations diffuse across different perceptions of space and time. They work with evolutionary senses, which though seemingly familiar, are tuned to hear, smell, see, taste, and feel in ways which bend human points of view.

Connect to the microbial cloud

As part of the project, working in the wetlab and mentored by Jake Wintermute, a synthetic biologist I began developing novel biological interfaces. This involved experimenting with growing interfaces with the intention of attracting more gossip to the home and body via skin. I called these ‘Objects of Attraction’. These living objects attract and rewild. They can be applied to skin to create an attraction layer and can be mated to create new variants.
The impetus for this came from research into efforts to thwart and repel other species in synthetic biology, through engineering the skin microbiome to actively repel creatures that are deemed unsuitable, unwanted. DARPA is at work on this. A consortium of biotech companies are part of a project known as ReVector, a program looking into how genetically engineering the skin-microbiome can create long-lasting, bacteria-based mosquito repellent.
When I heard this story it immediately triggered a thought: what if we rather than repel, we drew other species towards us, using that magical power, a sense of attraction.
Through research I was pointed to the complex world of pheromones, discovering gems such as Xt-109_polyphropenel, a pheromone that works wonders on Asian Elephants. It also attracts Monarch Butterflies and hundreds of types of moth. In essence a perfect manifestation of Interspecies Gossip. I decided to explore what might occur when we play with these pheromones to attract other beings, bringing more life and more gossip into the fray.
In order to create the attraction I worked with technology that has long since been developed in living systems. Yeasts are one of the first model organisms, and working with the scientists at Ginkgo Bioworks and CRI Paris, I learned that yeasts on their own attract other species due to the whiff of ethanol they emit, but that I could also modify the yeasts to emit particular pheromones to attract all manner of beings.
While we were unable to fully perform this due to time constraints, I explored this with a blend of speculative and real experiments working with Jake Wintermute and Sudeep Agarwal, who helped explain the principles of what might occur if we were to modify yeast to emit pheromones and then mate them to create new combinations.
In order to simulate how this could work, I worked with engineered strains of yeast, mating them to produce ‘compatible’ individuals. The results were a huge number of coloured yeasts. The colours helped me to keep track of their variations and the results of cross breeding.

Next, I began experimenting with biomaterials to create a skin type interface. This involved experimentation with many potential formulas, eventually settling on a formula based around agar-agar and amino acid growth media that would provide a nourishing habitat for the yeast to grow.
In the final step, I brought together yeasts and biomaterials to create Objects of Attraction. The objects created were based on the metaphor of ‘Soap’ - imagining a care product that could be applied to skin and would attract other species. A product that would also create a nourishing environment for the yeast.

Created in the context of a global pandemic, with people suffering from social isolation, touch deprivation, and increasing reliance on the digital cloud for connection, Interspecies Gossip presents an alternative hedonism, inviting you to embrace the nonhuman world, using your skin as a technology to connect to the microbial cloud.
Through this work, you are invited to explore the home in a new way, encountering the microbial cloud with the native technology of your skin. The skin’s true nature is revealed. Rather than being seen as a barrier or as a site to be cleansed of microbes, this practice emphasises the active skin-microbiome, a living interface. The eyes and ears of the body. A point of connection to another world.
3D Makeup: Ines Alpha
Graphic design: Henriette Kruse
Choreography: Marianna Minasova
Models: Jome Rain, Cheickne Sylla, Marianna Minasova

Project Details
Role
Concept creation
Creative direction
Synthetic biology
Bio-design
Scenario writing
Research
Year
2020
Exhibited
Ginkgo Creative Residency
Copernicus Museum

Interspecies gossip is a speculative fantasy and synthetic biology project revealing the conversations within, between and amongst communities of species that go unheard, unseen and undetected by human beings in their own homes.
It is a project comprised of a collection of stories, a set of 'Objects of Attraction' and a guide to a new practice, that might once again connect human beings with the nonhuman kin we live alongside.
The project is a journey through which we encounter chatty viruses, bored bacteria, intoxicated butterflies and heartbroken plants, accompanied by bodily rituals designed to help you get in touch with the nature of the home.
Interspecies Gossip gives a voice to the voiceless, creates a space for reconnection and allows us to indulge in some subversive fun.

Gossip with the multispecies

The first part of the project is a set of short stories, told from the perspective of gossiping organisms. While we might think gossip is a strictly human affair, other species do love to gossip.
They share stories about their past. Their love lives. Their darkest fears. Their hopes. They even gossip about the humans who live amongst them.
They use various languages and dialects ranging from chemical signatures, alluring odours and inaudible audio. Their conversations diffuse across different perceptions of space and time. They work with evolutionary senses, which though seemingly familiar, are tuned to hear, smell, see, taste, and feel in ways which bend human points of view.

Connect to the microbial cloud

As part of the project, working in the wetlab and mentored by Jake Wintermute, a synthetic biologist I began developing novel biological interfaces. This involved experimenting with growing interfaces with the intention of attracting more gossip to the home and body via skin. I called these ‘Objects of Attraction’. These living objects attract and rewild. They can be applied to skin to create an attraction layer and can be mated to create new variants.
The impetus for this came from research into efforts to thwart and repel other species in synthetic biology, through engineering the skin microbiome to actively repel creatures that are deemed unsuitable, unwanted. DARPA is at work on this. A consortium of biotech companies are part of a project known as ReVector, a program looking into how genetically engineering the skin-microbiome can create long-lasting, bacteria-based mosquito repellent.
When I heard this story it immediately triggered a thought: what if we rather than repel, we drew other species towards us, using that magical power, a sense of attraction.
Through research I was pointed to the complex world of pheromones, discovering gems such as Xt-109_polyphropenel, a pheromone that works wonders on Asian Elephants. It also attracts Monarch Butterflies and hundreds of types of moth. In essence a perfect manifestation of Interspecies Gossip. I decided to explore what might occur when we play with these pheromones to attract other beings, bringing more life and more gossip into the fray.
In order to create the attraction I worked with technology that has long since been developed in living systems. Yeasts are one of the first model organisms, and working with the scientists at Ginkgo Bioworks and CRI Paris, I learned that yeasts on their own attract other species due to the whiff of ethanol they emit, but that I could also modify the yeasts to emit particular pheromones to attract all manner of beings.
While we were unable to fully perform this due to time constraints, I explored this with a blend of speculative and real experiments working with Jake Wintermute and Sudeep Agarwal, who helped explain the principles of what might occur if we were to modify yeast to emit pheromones and then mate them to create new combinations.
In order to simulate how this could work, I worked with engineered strains of yeast, mating them to produce ‘compatible’ individuals. The results were a huge number of coloured yeasts. The colours helped me to keep track of their variations and the results of cross breeding.
Next, I began experimenting with biomaterials to create a skin type interface. This involved experimentation with many potential formulas, eventually settling on a formula based around agar-agar and amino acid growth media that would provide a nourishing habitat for the yeast to grow.
In the final step, I brought together yeasts and biomaterials to create Objects of Attraction. The objects created were based on the metaphor of ‘Soap’ - imagining a care product that could be applied to skin and would attract other species. A product that would also create a nourishing environment for the yeast.

Created in the context of a global pandemic, with people suffering from social isolation, touch deprivation, and increasing reliance on the digital cloud for connection, Interspecies Gossip presents an alternative hedonism, inviting you to embrace the nonhuman world, using your skin as a technology to connect to the microbial cloud.
Through this work, you are invited to explore the home in a new way, encountering the microbial cloud with the native technology of your skin. The skin’s true nature is revealed. Rather than being seen as a barrier or as a site to be cleansed of microbes, this practice emphasises the active skin-microbiome, a living interface. The eyes and ears of the body. A point of connection to another world.
3D Makeup: Ines Alpha
Graphic design: Henriette Kruse
Choreography: Marianna Minasova
Models: Jome Rain, Cheickne Sylla, Marianna Minasova
The project was created as part of the Ginkgo Bioworks Creative Residency, guided by advisors Christina Agapakis, Josh Dunn, Natsai Chieza and Grace Chuang.
© Cyrus Clarke 2025